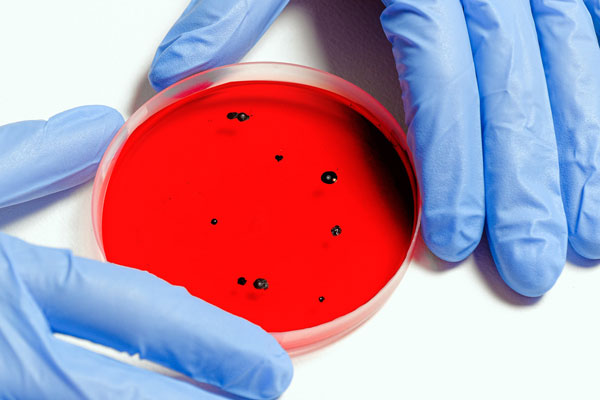
Роспотребнадзор: В России обнаружен южноафриканский штамм коронавируса

Новости ku66.ru
16 марта 2021 в 11:55
16 марта 2021
11 : 55
16 марта 2021 в 09:15
16 марта 2021
09 : 15
16 марта 2021 в 09:13
16 марта 2021
09 : 13
16 марта 2021 в 09:10
16 марта 2021
09 : 10
16 марта 2021 в 09:08
16 марта 2021
09 : 08
16 марта 2021 в 09:08
16 марта 2021
09 : 08
16 марта 2021 в 08:57
16 марта 2021
08 : 57
16 марта 2021 в 00:02
16 марта 2021
00 : 02
15 марта 2021 в 21:48
15 марта 2021
21 : 48
15 марта 2021 в 15:02
15 марта 2021
15 : 02
15 марта 2021 в 13:50
15 марта 2021
13 : 50
15 марта 2021 в 13:38
15 марта 2021
13 : 38
15 марта 2021 в 13:30
15 марта 2021
13 : 30
15 марта 2021 в 13:23
15 марта 2021
13 : 23
15 марта 2021 в 12:56
15 марта 2021
12 : 56
15 марта 2021 в 12:38
15 марта 2021
12 : 38
15 марта 2021 в 12:27
15 марта 2021
12 : 27
Реклама
Реклама. ООО "Новый дом" (ИНН 7452035298)
erid: 2VtzqvABtVK